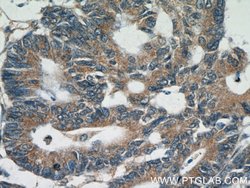
BCL2 Rabbit anti-Human, Polyclonal, Proteintech:Antibodies:Primary Antibodies

missing translation for 'onlineSavingsMsg'
Learn More
Learn More
BCL2 Rabbit anti-Human, Polyclonal, Proteintech
Rabbit Polyclonal Antibody
€ 145.00 - € 410.00
Specifications
| Antigen | BCL2 |
|---|---|
| Concentration | 0.3 mg/mL |
| Applications | Western Blot, Immunohistochemistry (Paraffin), Flow Cytometry, Immunoprecipitation |
| Classification | Polyclonal |
| Conjugate | Unconjugated |
| Product Code | Brand | Quantity | Price | Quantity & Availability | |||||
|---|---|---|---|---|---|---|---|---|---|
| Product Code | Brand | Quantity | Price | Quantity & Availability | |||||
|
16810694
|
Proteintech
12789-1-AP-20UL |
20 μL |
€ 145.00
20µL |
Please sign in to purchase this item. Need a web account? Register with us today! | |||||
|
16800694
|
Proteintech
12789-1-AP-150UL |
150 μL |
€ 410.00
150µL |
Please sign in to purchase this item. Need a web account? Register with us today! | |||||
Description
This antibody is not suitable for rat and mouse species.
BCL-2 is a key regulator of apoptosis that functions to either inhibit or promote cell death. The BCL-2 family members are also characterized by dimerizing to further modulate apoptosis. Bag1, for example, has been found to form a heterodimer with BCL-2 resulting in the enhancement of the anti-apoptotic effect of BCL-2. Bax and Bak have been shown to play a critical role in cytochrome c release from mitochondria and thus initiate apoptosis. Bax exerts a pro-apoptotic rather than an anti-apoptotic effect on cells. Constitutive expression of BCL2, such as in the case of translocation of BCL2 to Ig heavy chain locus, is thought to be the cause of follicular lymphoma. In most follicular lymphomas, neoplastic germinal centers express high levels of BCL-2 alpha protein, whereas the normal or hyperplastic germinal centers are negative. Two transcript variants of BCL-2, produced by alternate splicing, differ in their C-terminal ends. The overexpression of BCL-2 has been linked to human cancers such as B-cell lymphoma and prostate cancer.Specifications
| BCL2 | |
| Western Blot, Immunohistochemistry (Paraffin), Flow Cytometry, Immunoprecipitation | |
| Unconjugated | |
| Rabbit | |
| Human | |
| P10415 | |
| 596 | |
| BCL2 Fusion Protein Ag3508 | |
| Primary | |
| -20°C | |
| BCL2 |
| 0.3 mg/mL | |
| Polyclonal | |
| Liquid | |
| RUO | |
| PBS with 50% glycerol and 0.1% sodium azide; pH 7.3 | |
| Apoptosis regulator Bcl 2, B cell CLL/lymphoma 2, BCL2, BCL-2, Oncogene B cell leukemia 2 | |
| BCL2 | |
| IgG | |
| Antigen Affinity Chromatography | |
| Antibody |
Spot an opportunity for improvement?Share a Content Correction
Product Content Correction
Your input is important to us. Please complete this form to provide feedback related to the content on this product.
Product Title